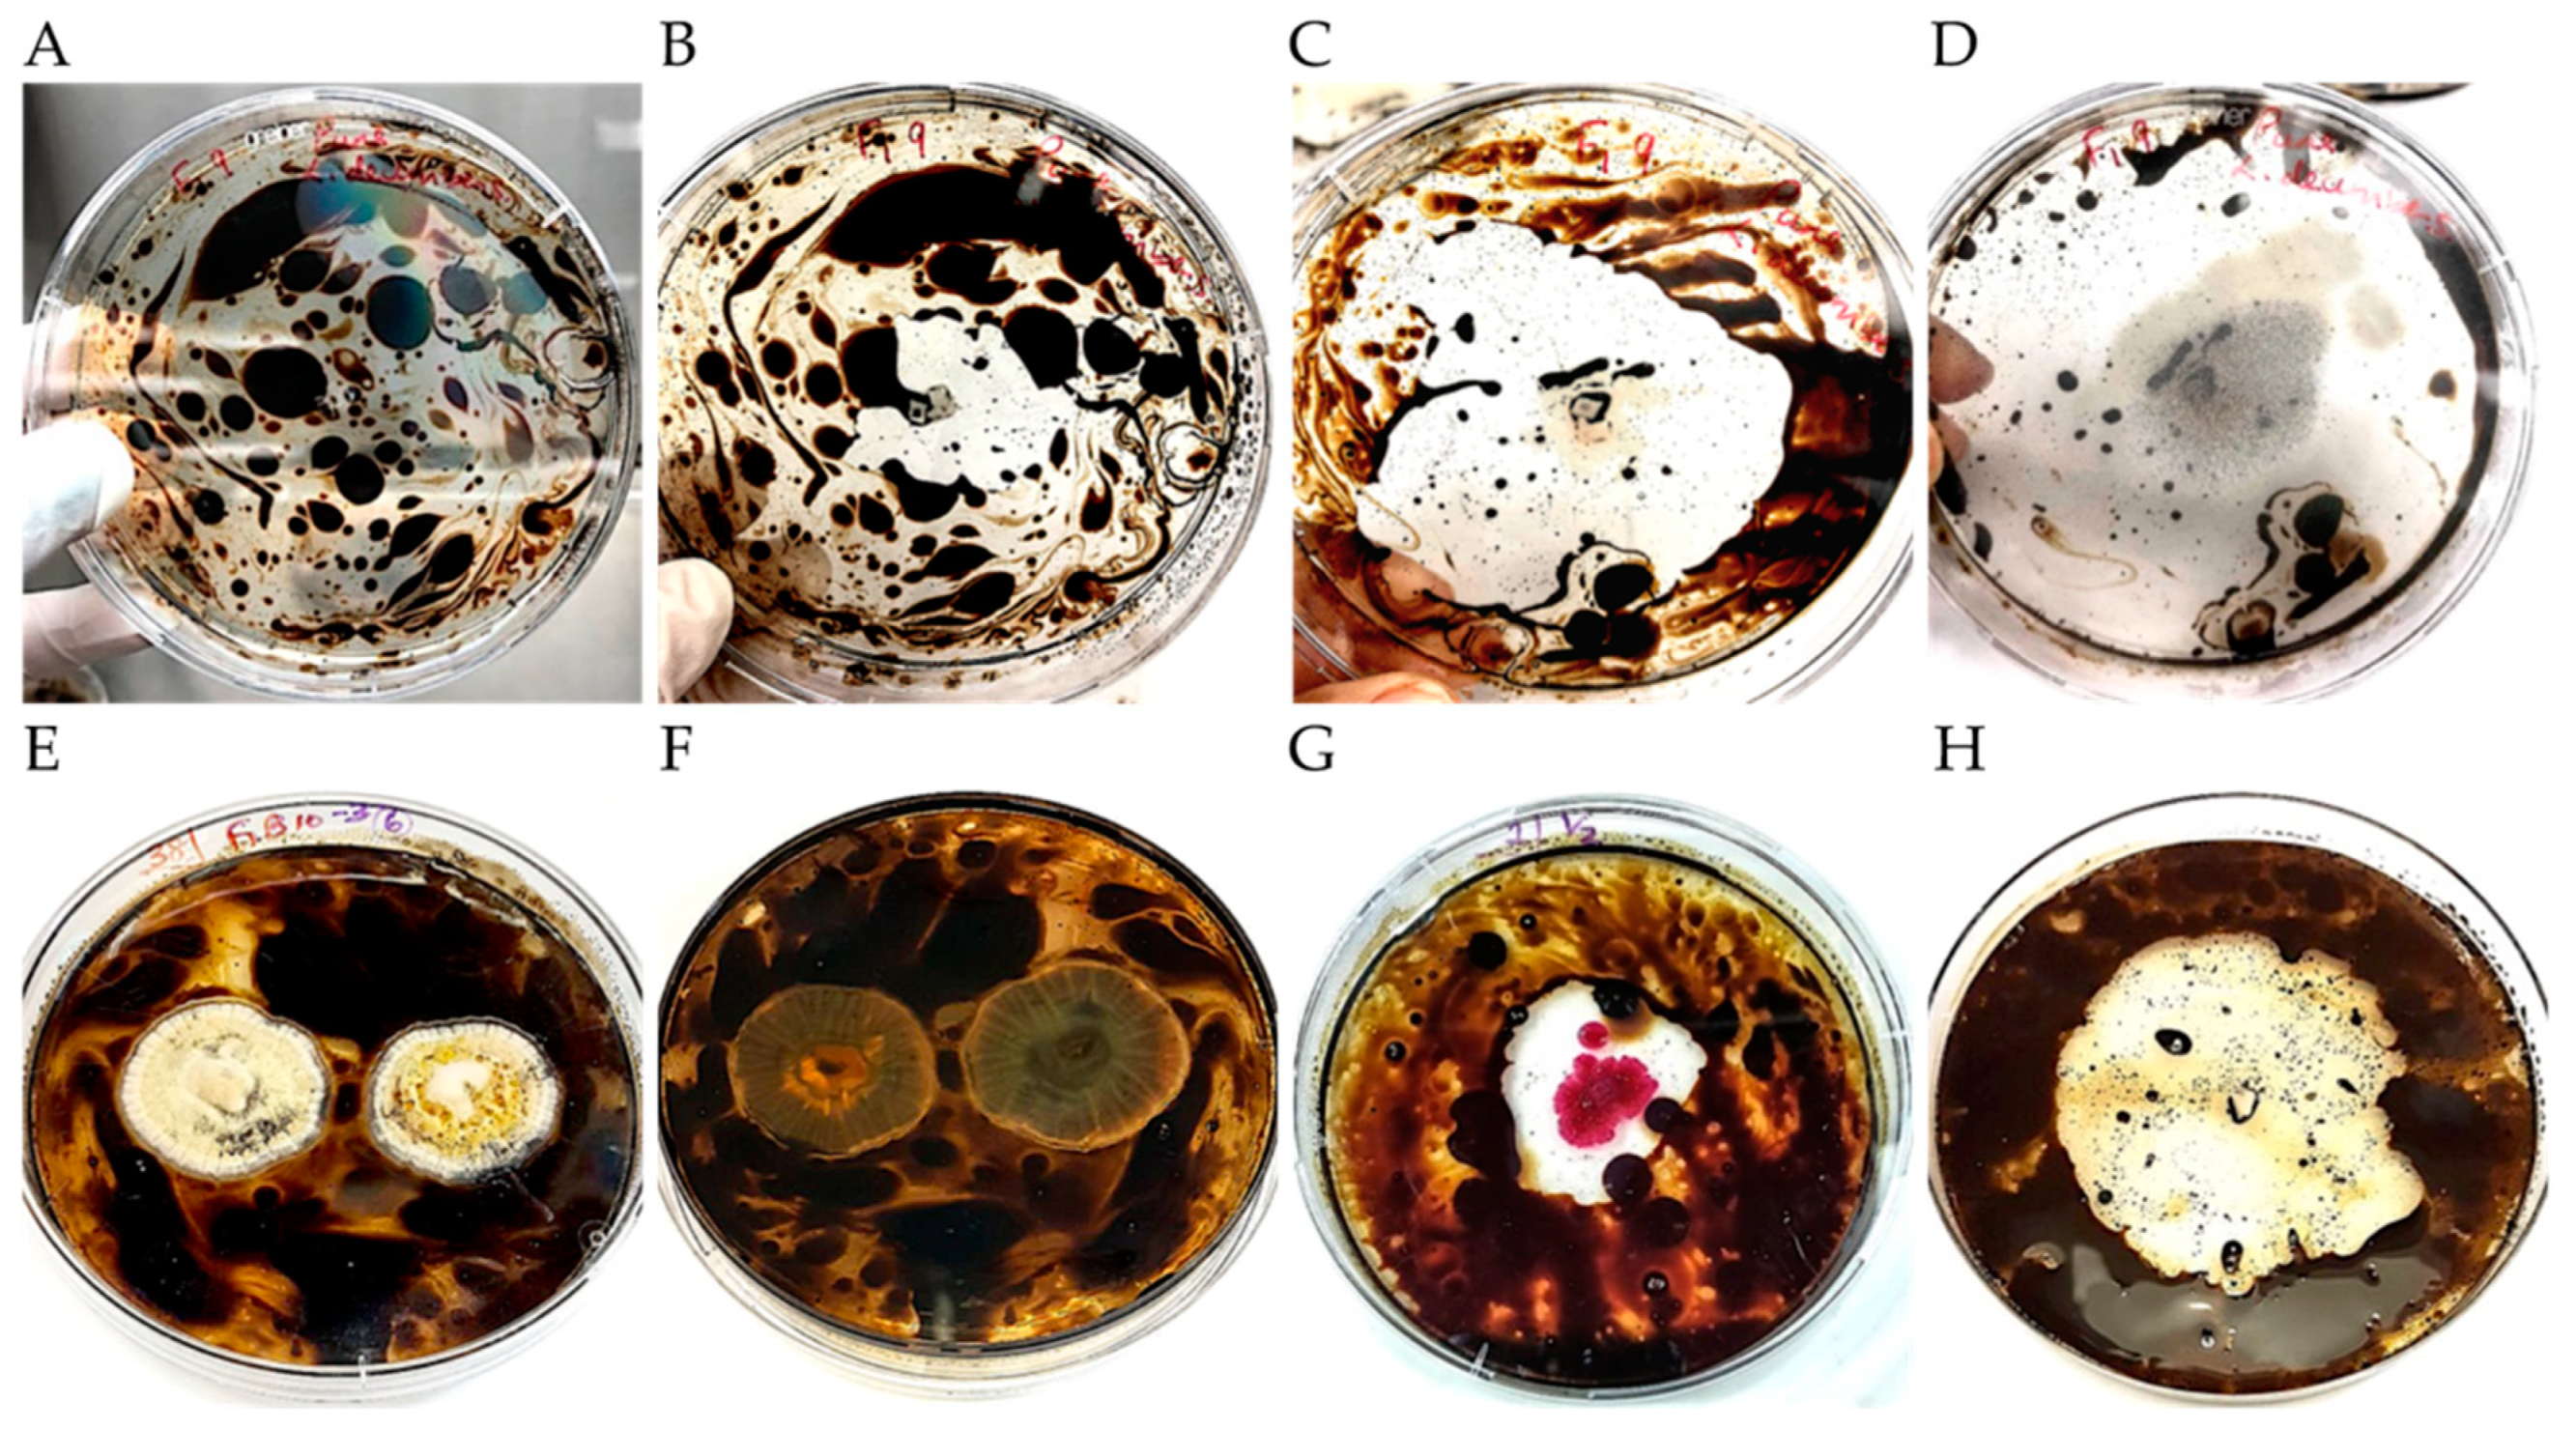
Microorganisms 09 01167 g002 Microorganisms 09 01167 g002
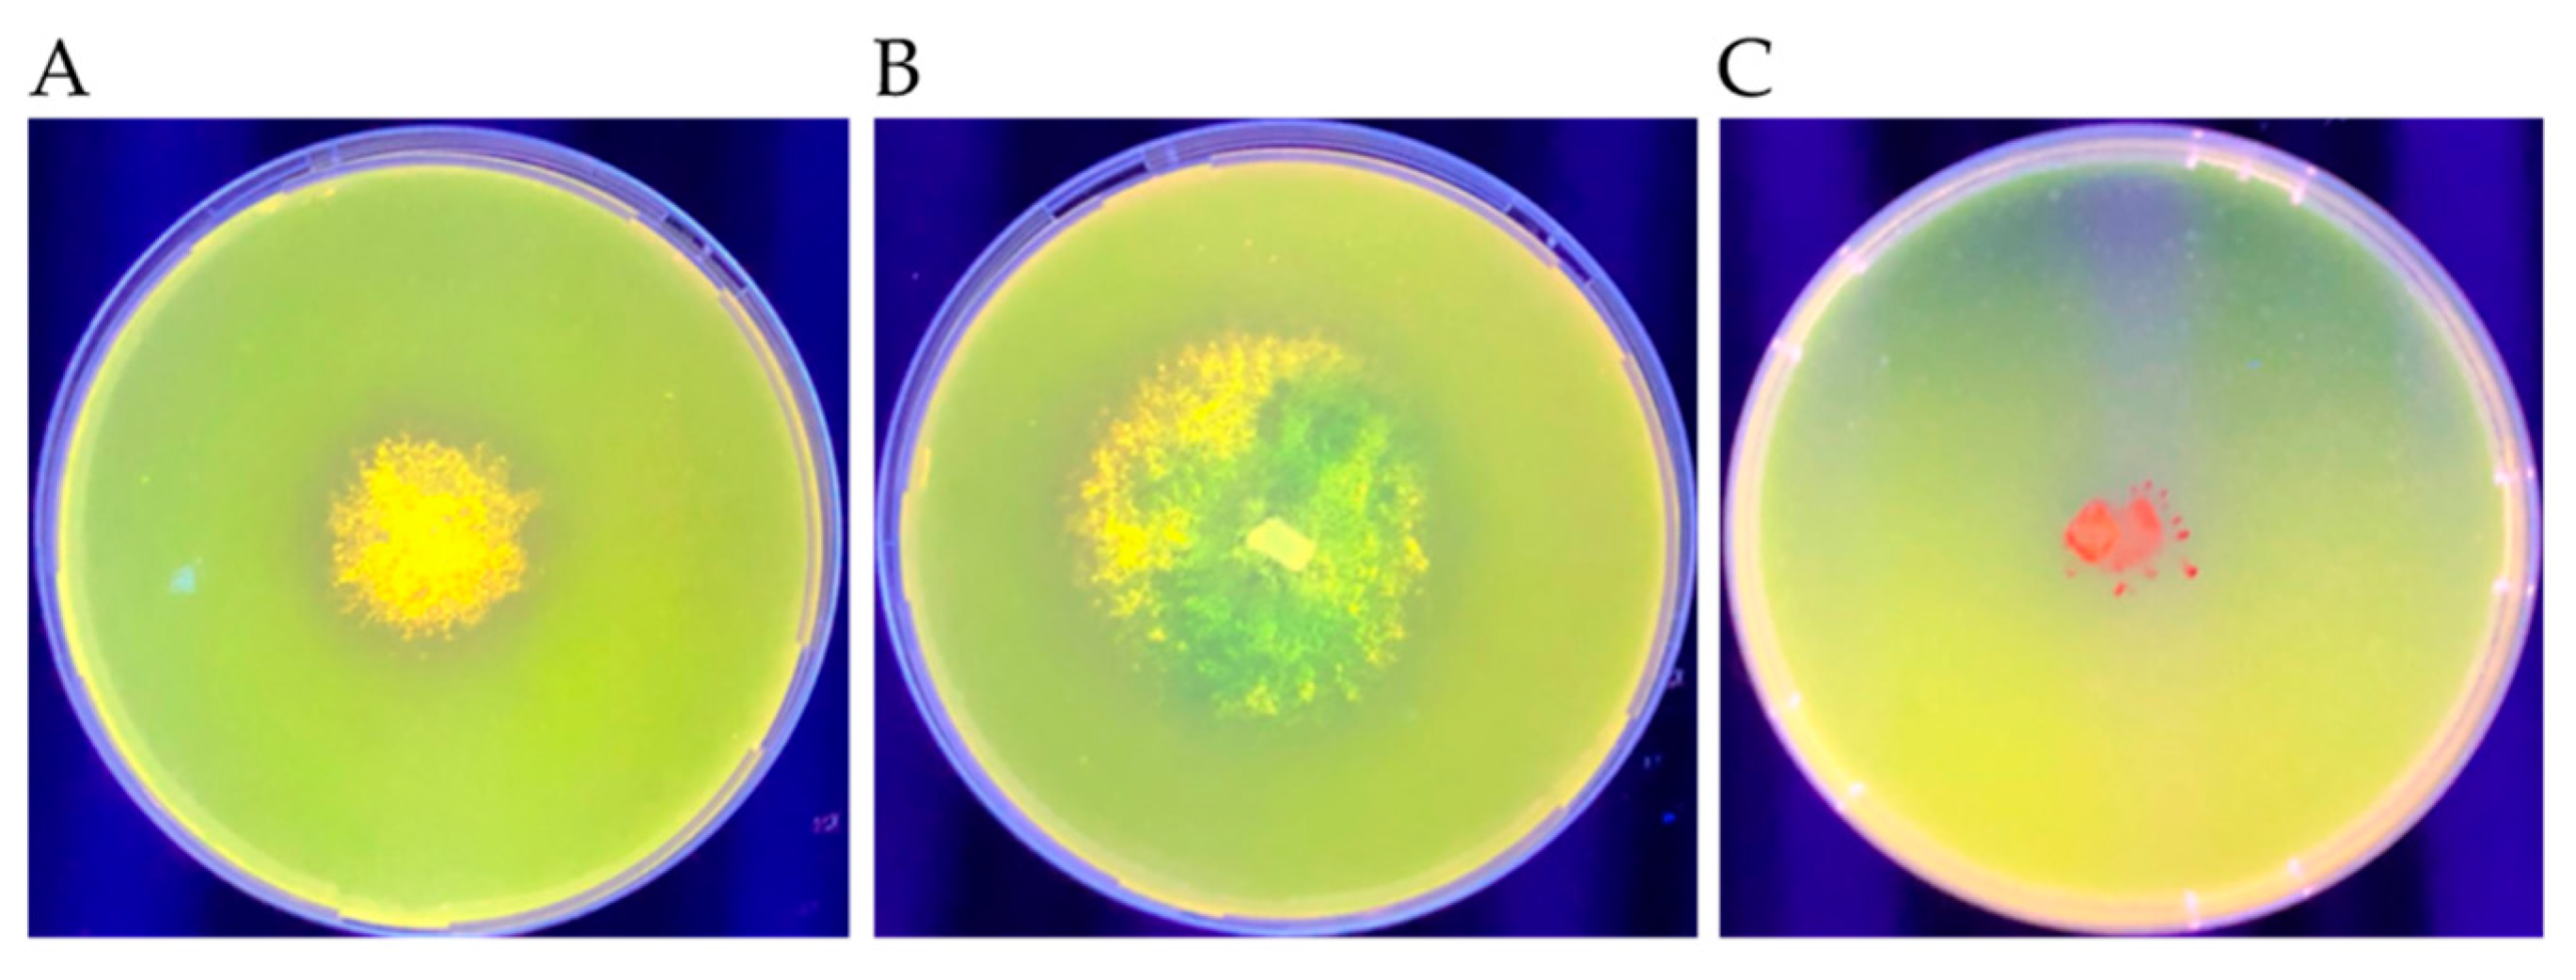
Microorganisms 09 01167 g006 Microorganisms 09 01167 g006

Diversity and Oil Degradation Potential of Culturable Microbes Isolated from Chronically Contaminated Soils in Trinidad
Abstract
1. Introduction
2. Materials and Methods
2.1. Site Descriptions
2.2. Soil Sampling and Isolation of Culturable Microbes
2.3. Isolation of Crude Oil-Degrading Microbes
2.4. Characterization of Growth on Crude Oil In vitro
2.5. Separation of Yeast–Bacteria Co-Cultures
2.6. Selection of Efficient Hydrocarbon-Utilizing Microbes
2.7. DNA Extraction, PCR, Sequencing, and Identification of Microbes
2.8. Extracellular Lipase Assay
2.9. Statistical Analyses
3. Results
3.1. Isolate Recovery
3.2. Isolation of Microbes from Contaminated Sites
3.3. Identification of Microbes with Demonstrated Oil-Degrading Capability in Vitro
3.4. Phylogenetic Analyses of Oil-Degrading Microbes
3.5. Extracellular Lipase Production
3.6. Fungi and Yeast Composition Among all Sites
3.7. Microbial Composition of Fungi and Yeast per Site
3.8. Diversity of Fungi and Yeast
3.9. Community Ordination and Clustering
4. Discussion
4.1. Fungi
4.2. Yeast
4.3. Co-isolated Bacteria
4.4. Extracellular Lipase Production
4.5. Novel Oil-Degraders from Trinidad
5. Conclusions
Supplementary Materials
Author Contributions
Funding
Institutional Review Board Statement
Informed Consent Statement
Data Availability Statement
Acknowledgments
Conflicts of Interest
References
- Macready, G.A. Petroleum industry of Trinidad. Trans. AIME 1921, 65, 58–68. [Google Scholar] [CrossRef]
- Mychajliw, A.M.; Mohammed, R.S.; Rice, K.A.; Farrell, A.B.; Rincón, A.D.; McAfee, R.; McDonald, H.G.; Lindsey, E.L. The biogeography of “breas”: Contextualizing the taphonomy, ecology, and diversity of Trinidad’s asphaltic fossil record. Quat. Sci. Rev. 2020, 232, 106179. [Google Scholar] [CrossRef]
- Persad, K.M.; Archie, C. History of petroleum exploration in Trinidad and Tobago. In Proceedings of the AAPG/SEG International Conference and Exhibition, Cancun, Mexico, 6–9 September 2016. [Google Scholar]
- Scribd. Offshore Seeps Study: Trinidad and Tobago 2018 Seepage Study. Available online: https://www.scribd.com/document/378203277/3693-17FY-NP-478-V1-Trinidad-Tobago-2017-300-v2 (accessed on 25 February 2021).
- Sutton, N.B.; Maphosa, F.; Morillo, J.A.; Al-Soud, W.A.; Langenhoff, A.A.M.; Grotenhuis, T.; Rijnaarts, H.H.M.; Smidt, H. Impact of long-term diesel contamination on soil microbial community structure. Appl. Environ. Microbiol. 2013, 79, 619–630. [Google Scholar] [CrossRef] [PubMed]
- Leahy, J.G.; Colwell, R.R. Microbial degradation of hydrocarbons in the environment. Microbiol. Mol. Biol. Rev. 1990, 54, 305–315. [Google Scholar] [CrossRef]
- Head, I.M.; Jones, D.M.; Röling, W.F.M. Marine microorganisms make a meal of oil. Nat. Rev. Microbiol. 2006, 4, 173–182. [Google Scholar] [CrossRef]
- Laffon, B.; Pásaro, E.; Valdiglesias, V. Effects of exposure to oil spills on human health: Updated review. J. Toxicol. Environ. Health Part B 2016, 19, 105–128. [Google Scholar] [CrossRef]
- Michel, J.; Fingas, M. Oil spills: Causes, consequences, prevention, and countermeasures. In Fossil Fuels: Current Status and Future Directions; Crawley, G.M., Ed.; World Scientific: Singapore, 2016; pp. 159–201. [Google Scholar]
- Al-Hawash, A.B.; Dragh, M.A.; Li, S.; Alhujaily, A.; Abbood, H.A.; Zhang, X.; Ma, F. Principles of microbial degradation of petroleum hydrocarbons in the environment. Egypt. J. Aquat. Res. 2018, 44, 71–76. [Google Scholar] [CrossRef]
- Duffy, J.J.; Peake, E.; Mohtadi, M.F. Oil spills on land as potential sources of groundwater contamination. Environ. Int. 1980, 3, 107–120. [Google Scholar] [CrossRef]
- Nadim, F.; Hoag, G.E.; Liu, S.; Carley, R.J.; Zack, P. Detection and remediation of soil and aquifer systems contaminated with petroleum products: An overview. J. Pet. Sci. Eng. 2000, 26, 169–178. [Google Scholar] [CrossRef]
- Doherty, V.F.; Otitoloju, A.A. Monitoring of soil and groundwater contamination following a pipeline explosion and petroleum product spillage in Ijegun, Lagos Nigeria. Environ. Monit. Assess. 2013, 185, 4159–4170. [Google Scholar] [CrossRef]
- Gross, S.A.; Avens, H.J.; Banducci, A.M.; Sahmel, J.; Panko, J.M.; Tvermoes, B.E. Analysis of BTEX groundwater concentrations from surface spills associated with hydraulic fracturing operations. J. Air Waste Manag. Assoc. 2013, 63. [Google Scholar] [CrossRef]
- Shores, A.; Laituri, M.; Butters, G. Produced water surface spills and the risk for BTEX and naphthalene groundwater contamination. Water Air Soil Pollut. 2017, 228, 1–13. [Google Scholar] [CrossRef]
- Rochman, F.F.; Sheremet, A.; Tamas, I.; Saidi-Mehrabad, A.; Kim, J.-J.; Dong, X.; Sensen, C.W.; Gieg, L.M.; Dunfield, P.F. Benzene and naphthalene degrading bacterial communities in an oil sands tailings pond. Front. Microbiol. 2017, 8, 1845. [Google Scholar] [CrossRef] [PubMed]
- Andersson, J.T.; Achten, C. A critical look at the 16 EPA PAHs. Polycycl. Aromat. Compd. 2015, 35, 143–146. [Google Scholar] [CrossRef]
- Ghosal, D.; Ghosh, S.; Dutta, T.K.; Ahn, Y. Current state of knowledge in microbial degradation of polycyclic aromatic hydrocarbons (PAHs): A review. Front. Microbiol. 2016, 7, 1369. [Google Scholar] [CrossRef]
- Alegbeleye, O.O.; Opeolu, B.O.; Jackson, V.A. Polycyclic aromatic hydrocarbons: A critical review of environmental occurrence and bioremediation. Environ. Manag. 2017, 60, 758–783. [Google Scholar] [CrossRef]
- Brown, L.D.; Ulrich, A.C.; Fingas, M. Bioremediation of oil spills on land. In Handbook of Oil Spill Science and Technology; Fingas, M., Ed.; John Wiley & Sons, Inc.: Hoboken, NJ, USA, 2015; Volume 724, pp. 395–406. [Google Scholar]
- Baniasadi, M.; Mousavi, S.M. A comprehensive review on the bioremediation of oil spills. In Microbial Action on Hydrocarbons; Kumar, V., Kumar, M., Prasad, R., Eds.; Springer: Singapore, 2018; pp. 223–254. [Google Scholar]
- Ali, N.; Dashti, N.; Khanafer, M.; Al-Awadhi, H.; Radwan, S. Bioremediation of soils saturated with spilled crude oil. Sci. Rep. 2020, 10, 1116. [Google Scholar] [CrossRef]
- Austin, R.; Callaghan, A. Microbial enzymes that oxidize hydrocarbons. Front. Microbiol. 2013, 4, 338. [Google Scholar] [CrossRef]
- Naing, S.-H.; Parvez, S.; Pender-Cudlip, M.; Groves, J.T.; Austin, R.N. Substrate specificity and reaction mechanism of purified alkane hydroxylase from the hydrocarbonoclastic bacterium Alcanivorax borkumensis (AbAlkB). J. Inorg. Biochem. 2013, 121, 46–52. [Google Scholar] [CrossRef]
- Obire, O.; Anyanwu, E.C. Impact of various concentrations of crude oil on fungal populations of soil. Int. J. Environ. Sci. Technol. 2009, 6, 211–218. [Google Scholar] [CrossRef]
- Makula, R.A.; Lockwood, P.J.; Finnerty, W.R. Comparative analysis of the lipids of Acinetobacter species grown on hexadecane. J. Bacteriol. 1975, 121, 250–258. [Google Scholar] [CrossRef]
- Wang, L.; Li, F.; Zhan, Y.; Zhu, L. Shifts in microbial community structure during in situ surfactant-enhanced bioremediation of polycyclic aromatic hydrocarbon-contaminated soil. Environ. Sci. Pollut. Res. 2016, 23, 14451–14461. [Google Scholar] [CrossRef]
- Bundy, J.G.; Paton, G.I.; Campbell, C.D. Microbial communities in different soil types do not converge after diesel contamination. J. Appl. Microbiol. 2002, 92, 276–288. [Google Scholar] [CrossRef]
- Powell, S.M.; Bowman, J.P.; Ferguson, S.H.; Snape, I. The importance of soil characteristics to the structure of alkane-degrading bacterial communities on sub-Antarctic Macquarie Island. Soil Biol. Biochem. 2010, 42, 2012–2021. [Google Scholar] [CrossRef]
- Hobbie, J.E.; Daley, R.J.; Jasper, S. Use of nuclepore filters for counting bacteria by fluorescence microscopy. Appl. Environ. Microbiol. 1977, 33, 1225–1228. [Google Scholar] [CrossRef]
- Roszak, D.B.; Colwell, R.R. Survival strategies of bacteria in the natural environment. Microbiol. Rev. 1987, 51, 365. [Google Scholar] [CrossRef] [PubMed]
- Yang, Y.; Wang, J.; Liao, J.; Xie, S.; Huang, Y. Distribution of naphthalene dioxygenase genes in crude oil-contaminated soils. Microb. Ecol. 2014, 68, 785–793. [Google Scholar] [CrossRef] [PubMed]
- Jiao, S.; Liu, Z.; Lin, Y.; Yang, J.; Chen, W.; Wei, G. Bacterial communities in oil contaminated soils: Biogeography and co-occurrence patterns. Soil Biol. Biochem. 2016, 98, 64–73. [Google Scholar] [CrossRef]
- Shin, B.; Kim, M.; Zengler, K.; Chin, K.-J.; Overholt, W.A.; Gieg, L.M.; Konstantinidis, K.T.; Kostka, J.E. Anaerobic degradation of hexadecane and phenanthrene coupled to sulfate reduction by enriched consortia from northern Gulf of Mexico seafloor sediment. Sci. Rep. 2019, 9, 1239. [Google Scholar] [CrossRef]
- Stefani, F.O.P.; Bell, T.H.; Marchand, C.; de la Providencia, I.E.; El Yassimi, A.E.; St-Arnaud, M.; Hijri, M. Culture-dependent and-independent methods capture different microbial community fractions in hydrocarbon-contaminated soils. PLoS ONE 2015, 10, e0128272. [Google Scholar] [CrossRef]
- Bhattacharya, D.; Sarma, P.M.; Krishnan, S.; Mishra, S.; Lal, B. Evaluation of genetic diversity among Pseudomonas citronellolis strains isolated from oily sludge-contaminated sites. Appl. Environ. Microbiol. 2003, 69, 1435–1441. [Google Scholar] [CrossRef]
- M’rassi, A.G.; Bensalah, F.; Gury, J.; Duran, R. Isolation and characterization of different bacterial strains for bioremediation of n-alkanes and polycyclic aromatic hydrocarbons. Environ. Sci. Pollut. Res. 2015, 22, 15332–15346. [Google Scholar] [CrossRef] [PubMed]
- El Mahdi, A.M.; Aziz, H.A.; Abu Amr, S.S.; El-Gendy, N.S.; Nassar, H.N. Isolation and characterization of Pseudomonas sp. NAF1 and its application in biodegradation of crude oil. Environ. Earth Sci. 2016, 75, 380. [Google Scholar] [CrossRef]
- Bell, T.H.; Stefani, F.O.P.; Abram, K.; Champagne, J.; Yergeau, E.; Hijri, M.; St-Arnaud, M. A diverse soil microbiome degrades more crude oil than specialized bacterial assemblages obtained in culture. Appl. Environ. Microbiol. 2016, 82, 5530. [Google Scholar] [CrossRef] [PubMed]
- Sun, J.-Q.; Xu, L.; Liu, X.-Y.; Zhao, G.-F.; Cai, H.; Nie, Y.; Wu, X.-L. Functional genetic diversity and culturability of petroleum-degrading bacteria isolated from oil-contaminated soils. Front. Microbiol. 2018, 9, 1332. [Google Scholar] [CrossRef]
- Gieg, L.M.; Fowler, S.J.; Berdugo-Clavijo, C. Syntrophic biodegradation of hydrocarbon contaminants. Curr. Opin. Biotechnol. 2014, 27, 21–29. [Google Scholar] [CrossRef] [PubMed]
- Juhasz, A.L.; Naidu, R. Bioremediation of high molecular weight polycyclic aromatic hydrocarbons: A review of the microbial degradation of benzo[a]pyrene. Int. Biodeterior. Biodegrad. 2000, 45, 57–88. [Google Scholar] [CrossRef]
- Harms, H.; Schlosser, D.; Wick, L.Y. Untapped potential: Exploiting fungi in bioremediation of hazardous chemicals. Nat. Rev. Microbiol. 2011, 9, 177–192. [Google Scholar] [CrossRef]
- Abbasian, F.; Lockington, R.; Mallavarapu, M.; Naidu, R. A comprehensive review of aliphatic hydrocarbon biodegradation by bacteria. Appl. Biochem. Biotechnol. 2015, 176, 670–699. [Google Scholar] [CrossRef]
- Booth, J.M.; Fusi, M.; Marasco, R.; Michoud, G.; Fodelianakis, S.; Merlino, G.; Daffonchio, D. The role of fungi in heterogeneous sediment microbial networks. Sci. Rep. 2019, 9, 7537. [Google Scholar] [CrossRef] [PubMed]
- Johnsen, A.R.; Wick, L.Y.; Harms, H. Principles of microbial PAH-degradation in soil. Environ. Pollut. 2005, 133, 71–84. [Google Scholar] [CrossRef] [PubMed]
- Saul, D.J.; Aislabie, J.M.; Brown, C.E.; Harris, L.; Foght, J.M. Hydrocarbon contamination changes the bacterial diversity of soil from around Scott Base, Antarctica. FEMS Microbiol. Ecol. 2005, 53, 141–155. [Google Scholar] [CrossRef] [PubMed]
- Al-Awadhi, H.; Dashti, N.; Khanafer, M.; Al-Mailem, D.; Ali, N.; Radwan, S. Bias problems in culture-independent analysis of environmental bacterial communities: A representative study on hydrocarbonoclastic bacteria. SpringerPlus 2013, 2, 1–11. [Google Scholar] [CrossRef]
- Bell, T.H.; Yergeau, E.; Maynard, C.; Juck, D.; Whyte, L.G.; Greer, C.W. Predictable bacterial composition and hydrocarbon degradation in Arctic soils following diesel and nutrient disturbance. ISME J. 2013, 7, 1200–1210. [Google Scholar] [CrossRef] [PubMed]
- dos Santos, H.F.; Cury, J.C.; do Carmo, F.L.; dos Santos, A.L.; Tiedje, J.; van Elsas, J.D.; Rosado, A.S.; Peixoto, R.S. Mangrove bacterial diversity and the impact of oil contamination revealed by pyrosequencing: Bacterial proxies for oil pollution. PLoS ONE 2011, 6, e16943. [Google Scholar] [CrossRef] [PubMed]
- Röling, W.F.M.; Milner, M.G.; Jones, D.M.; Lee, K.; Daniel, F.; Swannell, R.J.P.; Head, I.M. Robust hydrocarbon degradation and dynamics of bacterial communities during nutrient-enhanced oil spill bioremediation. Appl. Environ. Microbiol. 2002, 68, 5537–5548. [Google Scholar] [CrossRef]
- Kostka, J.E.; Prakash, O.; Overholt, W.A.; Green, S.J.; Freyer, G.; Canion, A.; Delgardio, J.; Norton, N.; Hazen, T.C.; Huettel, M. Hydrocarbon-degrading bacteria and the bacterial community response in Gulf of Mexico beach sands impacted by the Deepwater Horizon oil spill. Appl. Environ. Microbiol. 2011, 77, 7962–7974. [Google Scholar] [CrossRef]
- Vartoukian, S.R.; Palmer, R.M.; Wade, W.G. Strategies for culture of ‘unculturable’ bacteria. FEMS Microbiol. Lett. 2010, 309, 1–7. [Google Scholar] [CrossRef]
- Kugler, H.G. Geological Map of Trinidad; Petroleum Association of Trinidad: Port of Spain, Trinidad and Tobago, 1959. [Google Scholar]
- Chen, S.; Steel, R.J.; Dixon, J.F.; Osman, A. Facies and architecture of a tide-dominated segment of the late Pliocene Orinoco Delta (Morne L’Enfer Formation) SW Trinidad. Mar. Pet. Geol. 2014, 57, 208–232. [Google Scholar] [CrossRef]
- Dasgupta, S.; Buatois, L.A.; Zavala, C.; Mángano, M.G.; Törő, B. Ichnology of a subaqueously prograding clastic wedge, late Pliocene Morne L’Enfer Formation, Fullarton, Trinidad: Implications for recognition of autogenic erosional surfaces and delineation of stress factors on irregular echinoids. Palaeogeogr. Palaeoclimatol. Palaeoecol. 2016, 459, 365–380. [Google Scholar] [CrossRef]
- Baboolal, A.A.; Littke, R.; Wilson, B.; Stock, A.T.; Knight, J. Petrographical and geochemical characterization of lignites, sub-bituminous coals and carbonaceous sediments from the Erin Formation, Southern Basin, Trinidad: Implications on microfacies, depositional environment and organic matter alteration. Int. J. Coal Geol. 2016, 163, 112–122. [Google Scholar] [CrossRef]
- Hosein, R.; Bertrand, W.; Dawe, R. TRINIDAD EOR-1: More than 1 billion bbl of heavy oil remain onshore. Oil Gas J. 2011, 109, 62–69. [Google Scholar]
- Wach, G.D.; Vincent, H. Reservoir Heterogeneity and Characterization in Deltaic Depositional Systems-Outcrop Analogs for Heavy Oil and Oil Sand Developments. Available online: https://www.searchanddiscovery.com/pdfz/documents/2008/08019wach/images/wach.pdf.html (accessed on 1 May 2021).
- Khan, F.; Sastoo, J.; Ramlogan, V.; Ramnath, K. Mitigating the Health, Safety and Environmental Risks of an Enhanced Oil Recovery Project in a Tropical Forest. In Proceedings of the 11th Annual International Petroleum Environmental Conference, Albuquerque, NM, USA, 11–15 October 2004. [Google Scholar]
- White, T.J.; Bruns, T.; Lee, S.J.W.T.; Taylor, J.L. Amplification and direct sequencing of fungal ribosomal RNA genes for phylogenetics. In PCR Protocols: A Guide to Methods and Applications; Innis, M.A., Gelfand, D.H., Sninsky, J.J., White, T.J., Eds.; Academic Press: San Diego, CA, USA, 1990; Volume 18, pp. 315–322. [Google Scholar]
- Turner, S.; Pryer, K.M.; Miao, V.P.; Palmer, J.D. Investigating deep phylogenetic relationships among cyanobacteria and plastids by small subunit rRNA sequence analysis 1. J. Eukaryot. Microbiol. 1999, 46, 327–338. [Google Scholar] [CrossRef]
- Lane, D. 16S/23S rRNA sequencing. In Nucleic Acid Techniques in Bacterial Systematics; Stackebrandt, E., Goodfellow, M., Eds.; John Wiley and Sons: Chichester, NY, USA, 1991; pp. 115–175. [Google Scholar]
- Samson, R.A.; Visagie, C.M.; Houbraken, J.; Hong, S.B.; Hubka, V.; Klaassen, C.H.W.; Perrone, G.; Seifert, K.A.; Susca, A.; Tanney, J.B.; et al. Phylogeny, identification and nomenclature of the genus Aspergillus. Stud. Mycol. 2014, 78, 141–173. [Google Scholar] [CrossRef]
- Robert, L.V.; Szöke, S.; Eberhardt, U.; Cardinali, G.; Meyer, W.; Seifert, K.A.; Lévesque, C.A.; Lewis, C.T. The quest for a general and reliable fungal DNA barcode. Open Appl. Informat. J. 2011, 5, 45–61. [Google Scholar] [CrossRef]
- Short, D.P.G.; O’Donnell, K.; Thrane, U.; Nielsen, K.F.; Zhang, N.; Juba, J.H.; Geiser, D.M. Phylogenetic relationships among members of the Fusarium solani species complex in human infections and the descriptions of F. keratoplasticum sp. nov. and F. petroliphilum stat. nov. Fungal Genet. Biol. 2013, 53, 59–70. [Google Scholar] [CrossRef] [PubMed]
- Stielow, J.B.; Lévesque, C.A.; Seifert, K.A.; Meyer, W.; Iriny, L.; Smits, D.; Renfurm, R.; Verkley, G.J.M.; Groenewald, M.; Chaduli, D.; et al. One fungus, which genes? Development and assessment of universal primers for potential secondary fungal DNA barcodes. Persoonia 2015, 35, 242–263. [Google Scholar] [CrossRef]
- Hall, T.A. BioEdit: A user-friendly biology sequenc alignment editor and analysis program for Windows 95/98/NT. In Nucleic Acids Symposium Series; Information Retrieval Ltd.: London, UK, 1999; Volume 41, pp. 95–98. [Google Scholar]
- Altschul, S.F.; Gish, W.; Miller, W.; Myers, E.W.; Lipman, D.J. Basic local alignment search tool. J. Mol. Biol. 1990, 215, 403–410. [Google Scholar] [CrossRef]
- Kumar, S.; Stecher, G.; Li, M.; Knyaz, C.; Tamura, K. MEGA X: Molecular evolutionary genetics analysis across computing platforms. Mol. Biol. Evol. 2018, 35, 1547–1549. [Google Scholar] [CrossRef]
- Kouker, G.; Jaeger, K.E. Specific and sensitive plate assay for bacterial lipases. Appl. Environ. Microbiol. 1987, 53, 211–213. [Google Scholar] [CrossRef] [PubMed]
- Corbellini, V.A.; Scroferneker, M.L.; Carissimi, M.; Stopiglia, C.D.O.; Souza, T.F.D. Comparision of lipolytic activity of Sporothrix schenckii strains utilizing olive oil-rhodamine B and tween 80. Tecno-lógica Santa Cruz do Sul RS 2007, 11, 33–36. [Google Scholar]
- Kuzkova, N.; Popenko, O.; Yakunov, A. Application of temperature-dependent fluorescent dyes to the measurement of millimeter wave absorption in water applied to biomedical experiments. Int. J. Biomed. Imaging 2014, 2014, 243564. [Google Scholar] [CrossRef] [PubMed]
- RStudioTeam. RStudio: Integrated Development Environment for R, 1.3.1093 RStudio; PBC: Boston, MA, USA, 2020. [Google Scholar]
- Johnson, J.B.; Omland, K.S. Model selection in ecology and evolution. Trends Ecol. Evol. 2004, 19, 101–108. [Google Scholar] [CrossRef] [PubMed]
- Magurran, A.E. An index of diversity. In Measuring Biological Diversity; Blackwell Publishing: Malden, MA, USA, 2004; pp. 100–130. [Google Scholar]
- Chao, A. Nonparametric estimation of the number of classes in a population. Scand. J. Stat. 1984, 265–270. [Google Scholar]
- Simpson, E.H. Measurement of diversity. Nature 1949, 163, 688. [Google Scholar] [CrossRef]
- Whittaker, R.H. Dominance and diversity in land plant communities. Science 1965, 147, 250–260. [Google Scholar] [CrossRef] [PubMed]
- Wilson, J.B. Methods for fitting dominance/diversity curves. J. Veg. Sci. 1991, 2, 35–46. [Google Scholar] [CrossRef]
- Ngo-Massou, V.M.; Din, N.; Kenne, M.; Dongmo, A.B. Brachyuran crab diversity and abundance patterns in the mangroves of Cameroon. Reg. Stud. Mar. Sci. 2018, 24, 324–335. [Google Scholar] [CrossRef]
- Margesin, R.; Schinner, F. Effect of temperature on oil degradation by a psychrotrophic yeast in liquid culture and in soil. FEMS Microbiol. Ecol. 1997, 24, 243–249. [Google Scholar] [CrossRef]
- Atlas, R.M.; Bartha, R. Microbial Ecology: Fundamentals and Applications, 4th ed.; Benjamin Cummings: Menlo Park, CA, USA, 1998. [Google Scholar]
- Dean-Ross, D.; Moody, J.; Cerniglia, C.E. Utilization of mixtures of polycyclic aromatic hydrocarbons by bacteria isolated from contaminated sediment. FEMS Microbiol. Ecol. 2002, 41, 1–7. [Google Scholar] [CrossRef] [PubMed]
- Bundy, J.G.; Paton, G.I.; Campbell, C.D. Combined microbial community level and single species biosensor responses to monitor recovery of oil polluted soil. Soil Biol. Biochem. 2004, 36, 1149–1159. [Google Scholar] [CrossRef]
- Marchand, C.; St-Arnaud, M.; Hogland, W.; Bell, T.H.; Hijri, M. Petroleum biodegradation capacity of bacteria and fungi isolated from petroleum-contaminated soil. Int. Biodeterior. Biodegrad. 2017, 116, 48–57. [Google Scholar] [CrossRef]
- Mohammed, D.; Ramsubhag, A.; Beckles, D.M. An assessment of the biodegradation of petroleum hydrocarbons in contaminated soil using non-indigenous, commercial microbes. Water Air Soil Pollut. 2007, 182, 349–356. [Google Scholar] [CrossRef]
- Hosein, A. Isolation and Characterisation of Polycyclic Aromatic Hydrocarbon (PAH) Degrading Bacteria from the Soils Adjacent of the La Brea Pitch Lake Seepage. Master’s Thesis, University of the West Indies, St. Augustine, Trinidad and Tobago, West Indies, 2008. [Google Scholar]
- Meckenstock, R.U.; von Netzer, F.; Stumpp, C.; Lueders, T.; Himmelberg, A.M.; Hertkorn, N.; Schmitt-Kopplin, P.; Harir, M.; Hosein, R.; Haque, S.; et al. Water droplets in oil are microhabitats for microbial life. Science 2014, 345, 673. [Google Scholar] [CrossRef]
- Schulze-Makuch, D.; Haque, S.; de Sousa Antonio, M.R.; Ali, D.; Hosein, R.; Song, Y.C.; Yang, J.; Zaikova, E.; Beckles, D.M.; Guinan, E.; et al. Microbial life in a liquid asphalt desert. Astrobiology 2011, 11, 241–258. [Google Scholar] [CrossRef] [PubMed]
- Ramoutar, S.; Mohammed, A.; Ramsubhag, A. Laboratory-scale bioremediation potential of single and consortia fungal isolates from two natural hydrocarbon seepages in Trinidad, West Indies. Bioremediation J. 2019, 23, 131–141. [Google Scholar] [CrossRef]
- Siles, J.A.; Margesin, R. Insights into microbial communities mediating the bioremediation of hydrocarbon-contaminated soil from an alpine former military site. Appl. Microbiol. Biotechnol. 2018, 102, 4409–4421. [Google Scholar] [CrossRef]
- Spini, G.; Spina, F.; Poli, A.; Blieux, A.-L.; Regnier, T.; Gramellini, C.; Varese, G.C.; Puglisi, E. Molecular and microbiological insights on the enrichment procedures for the isolation of petroleum degrading bacteria and fungi. Front. Microbiol. 2018, 9, 2543. [Google Scholar] [CrossRef] [PubMed]
- Marco-Urrea, E.; García-Romera, I.; Aranda, E. Potential of non-ligninolytic fungi in bioremediation of chlorinated and polycyclic aromatic hydrocarbons. New Biotechnol. 2015, 32, 620–628. [Google Scholar] [CrossRef] [PubMed]
- Aranda, E. Promising approaches towards biotransformation of polycyclic aromatic hydrocarbons with Ascomycota fungi. Curr. Opin. Biotechnol. 2016, 38, 1–8. [Google Scholar] [CrossRef]
- Taha, H.; Shivanand, P.; Khoo, D.H.; Mohammad, Y.H.; Matussin, N.B.A.; Metali, F. Identification of culturable petroleum-degrading bacteria and fungi from petroleum-contaminated sites in Brunei Darussalam. J. Environ. Sci. Health Part A 2020, 1–6. [Google Scholar] [CrossRef] [PubMed]
- Zhang, J.H.; Xue, Q.H.; Gao, H.; Ma, X.; Wang, P. Degradation of crude oil by fungal enzyme preparations from Aspergillus spp. for potential use in enhanced oil recovery. J. Chem. Technol. Biotechnol. 2016, 91, 865–875. [Google Scholar] [CrossRef]
- Al-Hawash, A.B.; Zhang, X.; Ma, F. Removal and biodegradation of different petroleum hydrocarbons using the filamentous fungus Aspergillus sp. RFC-1. MicrobiologyOpen 2019, 8, e00619. [Google Scholar] [CrossRef] [PubMed]
- Wang, C.; Sun, H.; Li, J.; Li, Y.; Zhang, Q. Enzyme activities during degradation of polycyclic aromatic hydrocarbons by white rot fungus Phanerochaete chrysosporium in soils. Chemosphere 2009, 77, 733–738. [Google Scholar] [CrossRef]
- Chaillan, F.; Le Flèche, A.; Bury, E.; Phantavong, Y.-H.; Grimont, P.; Saliot, A.; Oudot, J. Identification and biodegradation potential of tropical aerobic hydrocarbon-degrading microorganisms. Res. Microbiol. 2004, 155, 587–595. [Google Scholar] [CrossRef]
- Al-Nasrawi, H. Biodegradation of crude oil by fungi isolated from Gulf of Mexico. J. Bioremediation Biodegrad. 2012, 3, 147. [Google Scholar] [CrossRef]
- Reyes-César, A.; Absalón, Á.E.; Fernández, F.J.; González, J.M.; Cortés-Espinosa, D.V. Biodegradation of a mixture of PAHs by non-ligninolytic fungal strains isolated from crude oil-contaminated soil. World J. Microbiol. Biotechnol. 2014, 30, 999–1009. [Google Scholar] [CrossRef] [PubMed]
- Morales, L.T.; González-García, L.N.; Orozco, M.C.; Restrepo, S.; Vives, M.J. The genomic study of an environmental isolate of Scedosporium apiospermum shows its metabolic potential to degrade hydrocarbons. Stand. Genom. Sci. 2017, 12. [Google Scholar] [CrossRef] [PubMed]
- Gałązka, A.; Grządziel, J.; Gałązka, R.; Gawryjołek, K.; Ukalska-Jaruga, A.; Smreczak, B. Fungal community, metabolic diversity, and glomalin-related soil proteins (grsp) content in soil contaminated with crude oil after long-term natural bioremediation. Front. Microbiol. 2020, 11, 572314. [Google Scholar] [CrossRef]
- Atlas, R.M. Microbial degradation of petroleum hydrocarbons: An environmental perspective. Microbiol. Rev. 1981, 45, 180–209. [Google Scholar] [CrossRef]
- Hughes, K.A.; Bridge, P.; Clark, M.S. Tolerance of Antarctic soil fungi to hydrocarbons. Sci. Total Environ. 2007, 372, 539–548. [Google Scholar] [CrossRef] [PubMed]
- Azarowicz, E.N. Microbial Degradation of Petroleum. U.S. Patent US3769164A, 30 October 1973. [Google Scholar]
- Li, Q.; Liu, J.; Gadd, G.M. Fungal bioremediation of soil co-contaminated with petroleum hydrocarbons and toxic metals. Appl. Microbiol. Biotechnol. 2020, 104, 8999–9008. [Google Scholar] [CrossRef] [PubMed]
- Nagano, Y.; Miura, T.; Nishi, S.; Lima, A.O.; Nakayama, C.; Pellizari, V.H.; Fujikura, K. Fungal diversity in deep-sea sediments associated with asphalt seeps at the Sao Paulo Plateau. Deep Sea Res. Part II Top. Stud. Oceanogr. 2017, 146, 59–67. [Google Scholar] [CrossRef]
- Poyntner, C.; Prem, M.; Mann, O.; Blasi, B.; Sterflinger, K. Selective screening: Isolation of fungal strains from contaminated soils in Austria. Die Bodenkult. J. Land Manag. Food Environ. 2018, 68, 157–169. [Google Scholar] [CrossRef][Green Version]
- Lee, A.H.; Lee, H.; Heo, Y.M.; Lim, Y.W.; Kim, C.-M.; Kim, G.-H.; Chang, W.; Kim, J.-J. A proposed stepwise screening framework for the selection of polycyclic aromatic hydrocarbon (PAH)-degrading white rot fungi. Bioprocess Biosyst. Eng. 2020, 43, 767–783. [Google Scholar] [CrossRef]
- Marín, F.; Navarrete, H.; Narvaez-Trujillo, A. Total petroleum hydrocarbon degradation by endophytic fungi from the Ecuadorian Amazon. Adv. Appl. Microbiol. 2018, 8, 1029–1053. [Google Scholar] [CrossRef]
- Sim, C.S.F.; Chen, S.H.; Ting, A.S.Y. Endophytes: Emerging tools for the bioremediation of pollutants. In Emerging and Eco-Friendly Approaches for Waste Management; Bharagava, R.N., Chowdhary, P., Eds.; Springer: Singapore, 2019; pp. 189–217. [Google Scholar]
- Chaıneau, C.; Morel, J.; Dupont, J.; Bury, E.; Oudot, J. Comparison of the fuel oil biodegradation potential of hydrocarbon-assimilating microorganisms isolated from a temperate agricultural soil. Sci. Total Environ. 1999, 227, 237–247. [Google Scholar] [CrossRef]
- Ravelet, C.; Krivobok, S.; Sage, L.; Steiman, R. Biodegradation of pyrene by sediment fungi. Chemosphere 2000, 40, 557–563. [Google Scholar] [CrossRef]
- Li, H.-Y.; Wei, D.-Q.; Shen, M.; Zhou, Z.-P. Endophytes and their role in phytoremediation. Fungal Divers. 2012, 54, 11–18. [Google Scholar] [CrossRef]
- Krishnamurthy, Y.L.; Naik, B.S. Endophytic fungi bioremediation. In Endophytes: Crop Productivity and Protection; Maheshwari, D.K., Annapurna, K., Eds.; Springer: Cham, Germany, 2017; pp. 47–60. [Google Scholar]
- Malafatti-Picca, L.; de Barros Chaves, M.R.; de Castro, A.M.; Valoni, É.; de Oliveira, V.M.; Marsaioli, A.J.; de Angelis, D.D.F.; Attili-Angelis, D. Hydrocarbon-associated substrates reveal promising fungi for poly (ethylene terephthalate) (PET) depolymerization. Braz. J. Microbiol. 2019, 50, 633–648. [Google Scholar] [CrossRef]
- Cerniglia, C.E.; Sutherland, J.B. Degradation of polycyclic aromatic hydrocarbons by fungi. In Handbook of Hydrocarbon and Lipid Microbiology; Timmis, K.N., Ed.; Springer: Berlin/Heidelberg, Germany, 2010; pp. 2079–2110. [Google Scholar]
- da Silva, M.; Umbuzeiro, G.A.; Pfenning, L.H.; Canhos, V.P.; Esposito, E. Filamentous fungi isolated from estuarine sediments contaminated with industrial discharges. Soil Sediment Contam 2003, 12, 345–356. [Google Scholar] [CrossRef]
- Garon, D.; Sage, L.; Seigle-Murandi, F. Effects of fungal bioaugmentation and cyclodextrin amendment on fluorene degradation in soil slurry. Biodegradation 2004, 15, 1–8. [Google Scholar] [CrossRef]
- Sandhu, S.S.; Shakya, M.; Deshmukh, L.; Aharwal, R.P.; Kumar, S. Determination of hydrocarbon degrading potentiality of indigenous fungal isolates. Int. J. Environ. Sci. 2016, 6, 1163–1172. [Google Scholar] [CrossRef]
- Anoliefo, G.O.; Ikhajiagbe, B.; Berena, A.T.; Okoro, R.E. Bioremediation of crude oil-polluted soil by using Vernonia amagdylina and manure. Int. Res. J. Biotechnol. 2010, 1, 37–43. [Google Scholar]
- Bovio, E.; Gnavi, G.; Prigione, V.; Spina, F.; Denaro, R.; Yakimov, M.; Calogero, R.; Crisafi, F.; Varese, G.C. The culturable mycobiota of a Mediterranean marine site after an oil spill: Isolation, identification and potential application in bioremediation. Sci. Total Environ. 2017, 576, 310–318. [Google Scholar] [CrossRef]
- Fan, C.-Y.; Krishnamurthy, S. Enzymes for enhancing bioremediation of petroleum-contaminated soils: A brief review. J. Air Waste Manag. Assoc. 1995, 45, 453–460. [Google Scholar] [CrossRef][Green Version]
- Mueller, J.G.; Cerniglia, C.E.; Pritchard, P.H. Bioremediation of environments contaminated by polycyclic aromatic hydrocarbons. In Bioremediation: Principles and Applications; Crawford, R.L., Crawford, D.L., Eds.; Cambridge University Press: Cambridge, UK, 1996; Volume 6, pp. 125–194. [Google Scholar]
- Naranjo-Briceño, L.; Pernía, B.; Perdomo, T.; González, M.; Inojosa, Y.; De Sisto, Á.; Urbina, H.; León, V. Potential role of extremophilic hydrocarbonoclastic fungi for extra-heavy crude oil bioconversion and the sustainable development of the petroleum industry. In Fungi in Extreme Environments: Ecological Role and Biotechnological Significance; Tiquia-Arashiro, S.M., Grube, M., Eds.; Springer: Cham, Germany, 2019; pp. 559–586. [Google Scholar]
- Okino, L.K.; Machado, K.M.G.; Fabris, C.; Bononi, V.L.R. Ligninolytic activity of tropical rainforest basidiomycetes. World J. Microbiol. Biotechnol. 2000, 16, 889–893. [Google Scholar] [CrossRef]
- Chen, R.; Zhou, Z.; Liu, Y.; Jiang, J.; Li, Q.; Song, H.; Pei, D.; Xu, H. Mycoremediation potential and tolerance responses of Oudemansiella radicata in cadmium-pyrene co-contaminated soil. J. Soils Sediments. 2015, 15, 1083–1093. [Google Scholar] [CrossRef]
- Ghizelini, A.M.; Martins, K.G.; Gießelmann, U.C.; Santoro, E.; Pasqualette, L.; Mendonça-Hagler, L.C.; Rosado, A.S.; Macrae, A. Fungal communities in oil contaminated mangrove sediments–who is in the mud? Mar. Pollut. Bull. 2019, 139, 181–188. [Google Scholar] [CrossRef]
- Middlehoven, W.J. Catabolism of benzene compounds by ascomycetous and basidiomycetous yeasts and yeast-like fungi. Antonie van Leeuwenhoek 1993, 63, 125–144. [Google Scholar] [CrossRef]
- Prenafeta-Boldú, F.X.; de Hoog, G.S.; Summerbell, R.C. Fungal communities in hydrocarbon degradation. In Microbial Communities Utilizing Hydrocarbons and Lipids: Members, Metagenomics and Ecophysiology. Handbook of Hydrocarbon and Lipid Microbiology; McGenity, T.J., Ed.; Springer: Cham, Germany, 2018; pp. 1–36. [Google Scholar]
- Yalçın, H.T.; Ergin-Tepebaşı, G.; Uyar, E. Isolation and molecular characterization of biosurfactant producing yeasts from the soil samples contaminated with petroleum derivatives. J. Basic Microbiol. 2018, 58, 782–792. [Google Scholar] [CrossRef] [PubMed]
- Mikolasch, A.; Donath, M.; Reinhard, A.; Herzer, C.; Zayadan, B.; Urich, T.; Schauer, F. Diversity and degradative capabilities of bacteria and fungi isolated from oil-contaminated and hydrocarbon-polluted soils in Kazakhstan. Appl. Microbiol. Biotechnol. 2019, 103, 7261–7274. [Google Scholar] [CrossRef]
- Hashem, M.; Alamri, S.A.; Al-Zomyh, S.S.A.A.; Alrumman, S.A. Biodegradation and detoxification of aliphatic and aromatic hydrocarbons by new yeast strains. Ecotoxicol. Environ. Saf. 2018, 151, 28–34. [Google Scholar] [CrossRef]
- Romero, M.C.; Salvioli, M.L.; Cazau, M.C.; Arambarri, A.M. Pyrene degradation by yeasts and filamentous fungi. Environ. Pollut. 2002, 117, 159–163. [Google Scholar] [CrossRef]
- Miranda, R.d.C.; Souza, C.S.d.; Gomes, E.d.B.; Lovaglio, R.B.; Lopes, C.E.; Sousa, M.d.F.V.d.Q. Biodegradation of diesel oil by yeasts isolated from the vicinity of Suape Port in the state of Pernambuco-Brazil. Braz. Arch. Biol. Technol. 2007, 50, 147–152. [Google Scholar] [CrossRef]
- Chandran, P.; Das, N. Role of plasmid in diesel oil degradation by yeast species isolated from petroleum hydrocarbon-contaminated soil. Environ. Technol. 2012, 33, 645–652. [Google Scholar] [CrossRef] [PubMed]
- Wang, Q.-M.; Begerow, D.; Groenewald, M.; Liu, X.-Z.; Theelen, B.; Bai, F.-Y.; Boekhout, T. Multigene phylogeny and taxonomic revision of yeasts and related fungi in the Ustilaginomycotina. Stud. Mycol. 2015, 81, 55–83. [Google Scholar] [CrossRef] [PubMed]
- Liu, Y.; Zou, Z.; Hu, Z.; Wang, W.; Xiong, J. Morphology and molecular analysis of Moesziomyces antarcticus isolated from the blood samples of a Chinese patient. Front. Microbiol. 2019, 10, 254. [Google Scholar] [CrossRef]
- Martin-Sanchez, P.M.; Becker, R.; Gorbushina, A.A.; Toepel, J. An improved test for the evaluation of hydrocarbon degradation capacities of diesel-contaminating microorganisms. Int. Biodeterior. Biodegrad. 2018, 129, 89–94. [Google Scholar] [CrossRef]
- Cerniglia, C.E. Fungal metabolism of polycyclic aromatic hydrocarbons: Past, present and future applications in bioremediation. J. Ind. Microbiol. Biotechnol. 1997, 19, 324–333. [Google Scholar] [CrossRef]
- Cerniglia, C.E.; Sutherland, J.B. Bioremediation of polycyclic aromatic hydrocarbons by ligninolytic and non-ligninolytic fungi. In Fungi in Bioremediation; Gadd, G.M., Ed.; Cambridge University Press: Cambridge, UK, 2001; Volume 23, pp. 136–187. [Google Scholar]
- Francis, M. A Preliminary Investigation of Marine Yeast Biodiversity in New Zealand Waters. Master’s Thesis, Victoria University of Wellington, Wellington, New Zealand, 2013. [Google Scholar]
- Chaudhary, D.K.; Kim, J. Chryseobacterium nepalense sp. nov., isolated from oil-contaminated soil. Int. J. Syst. Evol. Microbiol. 2017, 67, 646–652. [Google Scholar] [CrossRef]
- Borah, D.; Agarwal, K.; Khataniar, A.; Konwar, D.; Gogoi, S.B.; Kallel, M. A newly isolated strain of Serratia sp. from an oil spillage site of Assam shows excellent bioremediation potential. 3 Biotech 2019, 9, 283. [Google Scholar] [CrossRef]
- Gałązka, A.; Grządziel, J.; Gałązka, R.; Ukalska-Jaruga, A.; Strzelecka, J.; Smreczak, B. Genetic and functional diversity of bacterial microbiome in soils with long term impacts of petroleum hydrocarbons. Front. Microbiol. 2018, 9, 1923. [Google Scholar] [CrossRef]
- Borowik, A.; Wyszkowska, J. Remediation of soil contaminated with diesel oil. J. Elem. 2018, 23, 767–788. [Google Scholar] [CrossRef]
- Inoue, K.; Habe, H.; Yamane, H.; Omori, T.; Nojiri, H. Diversity of carbazole-degrading bacteria having the car gene cluster: Isolation of a novel gram-positive carbazole-degrading bacterium. FEMS Microbiol. Lett. 2005, 245, 145–153. [Google Scholar] [CrossRef] [PubMed]
- Weiland-Bräuer, N.; Fischer, M.A.; Schramm, K.-W.; Schmitz, R.A. Polychlorinated biphenyl (pcb)-degrading potential of microbes present in a cryoconite of Jamtalferner Glacier. Front. Microbiol. 2017, 8. [Google Scholar] [CrossRef] [PubMed]
- Saimmai, A.; Kaewrueng, J.; Maneerat, S. Used lubricating oil degradation and biosurfactant production by SC-9 consortia obtained from oil-contaminated soil. Ann. Microbiol. 2012, 62, 1757–1767. [Google Scholar] [CrossRef]
- Guo, W.; Li, D.; Tao, Y.; Gao, P.; Hu, J. Isolation and description of a stable carbazole-degrading microbial consortium consisting of Chryseobacterium sp. NCY and Achromobacter sp. NCW. Curr. Microbiol. 2008, 57, 251. [Google Scholar] [CrossRef]
- Wongsa, P.; Tanaka, M.; Ueno, A.; Hasanuzzaman, M.; Yumoto, I.; Okuyama, H. Isolation and characterization of novel strains of Pseudomonas aeruginosa and Serratia marcescens possessing high efficiency to degrade gasoline, kerosene, diesel oil, and lubricating oil. Curr. Microbiol. 2004, 49, 415–422. [Google Scholar] [CrossRef] [PubMed]
- Kotoky, R.; Singha, L.P.; Pandey, P. Draft genome sequence of heavy metal-resistant soil bacterium Serratia marcescens S2I7, which has the ability to degrade polyaromatic hydrocarbons. Genome Announc. 2017, 5. [Google Scholar] [CrossRef]
- Guo, G.; Tian, F.; Ding, K.; Wang, L.; Liu, T.; Yang, F. Effect of a bacterial consortium on the degradation of polycyclic aromatic hydrocarbons and bacterial community composition in Chinese soils. Int. Biodeterior. Biodegrad. 2017, 123, 56–62. [Google Scholar] [CrossRef]
- Denef, V.J.; Klappenbach, J.A.; Patrauchan, M.A.; Florizone, C.; Rodrigues, J.L.M.; Tsoi, T.V.; Verstraete, W.; Eltis, L.D.; Tiedje, J.M. Genetic and genomic insights into the role of benzoate-catabolic pathway redundancy in Burkholderia xenovorans LB400. Appl. Environ. Microbiol. 2006, 72, 585–595. [Google Scholar] [CrossRef]
- Jaeger, K.-E.; Reetz, M.T. Microbial lipases form versatile tools for biotechnology. Trends Biotechnol. 1998, 16, 396–403. [Google Scholar] [CrossRef]
- Margesin, R.; Zimmerbauer, A.; Schinner, F. Soil lipase activity-a useful indicator of oil biodegradation. Biotechnol. Tech. 1999, 13, 859–863. [Google Scholar] [CrossRef]
- Gupta, R.; Gupta, N.; Rathi, P. Bacterial lipases: An overview of production, purification and biochemical properties. Appl. Microbiol. Biotechnol. 2004, 64, 763–781. [Google Scholar] [CrossRef] [PubMed]
- Magan, N.; Fragoeiro, S.; Bastos, C. Environmental factors and bioremediation of xenobiotics using white rot fungi. Mycobiology 2010, 38, 238–248. [Google Scholar] [CrossRef]
- Treichel, H.; de Oliveira, D.; Mazutti, M.A.; Di Luccio, M.; Oliveira, J.V. A review on microbial lipases production. Food Bioprocess Technol. 2010, 3, 182–196. [Google Scholar] [CrossRef]
- Sharma, R.; Chisti, Y.; Banerjee, U.C. Production, purification, characterization, and applications of lipases. Biotechnol. Adv. 2001, 19, 627–662. [Google Scholar] [CrossRef]
- Patowary, K.; Patowary, R.; Kalita, M.C.; Deka, S. Development of an efficient bacterial consortium for the potential remediation of hydrocarbons from contaminated sites. Front. Microbiol. 2016, 7, 1092. [Google Scholar] [CrossRef] [PubMed]
- Fuentes, S.; Méndez, V.; Aguila, P.; Seeger, M. Bioremediation of petroleum hydrocarbons: Catabolic genes, microbial communities, and applications. Appl. Microbiol. Biotechnol. 2014, 98, 4781–4794. [Google Scholar] [CrossRef]
- Zengler, K.; Toledo, G.; Rappé, M.; Elkins, J.; Mathur, E.J.; Short, J.M.; Keller, M. Cultivating the uncultured. Proc. Natl. Acad. Sci. USA 2002, 99, 15681–15686. [Google Scholar] [CrossRef] [PubMed]
- Liao, J.; Wang, J.; Huang, Y. Bacterial community features are shaped by geographic location, physicochemical properties, and oil contamination of soil in main oil fields of China. Microb. Ecol. 2015, 70, 380–389. [Google Scholar] [CrossRef] [PubMed]
- Gao, P.; Tian, H.; Wang, Y.; Li, Y.; Li, Y.; Xie, J.; Zeng, B.; Zhou, J.; Li, G.; Ma, T. Spatial isolation and environmental factors drive distinct bacterial and archaeal communities in different types of petroleum reservoirs in China. Sci. Rep. 2016, 6, 20174. [Google Scholar] [CrossRef]
- Marchand, C.; Jani, Y.; Kaczala, F.; Hijri, M.; Hogland, W. Physicochemical and ecotoxicological characterization of petroleum hydrocarbons and trace elements contaminated soil. Polycycl. Aromat. Compd. 2020, 40, 967–978. [Google Scholar] [CrossRef]
- McGenity, T.J.; Folwell, B.D.; McKew, B.A.; Sanni, G.O. Marine crude-oil biodegradation: A central role for interspecies interactions. Aquat. Biosyst. 2012, 8, 10. [Google Scholar] [CrossRef] [PubMed]

| Locality | Formation | Depth (ft) | Porosity (%) | Permeability (md) | Oil Gravity | Viscosity | Oil Saturation | Site Type |
|---|---|---|---|---|---|---|---|---|
| Pablito (P) | Morne L’Enfer | 1200–1700 | 28 | 250 | 13–21 | 160–550 | 65–75 | Forest |
| Fyzabad Forest Reserve (F) | Morne L’Enfer | 1200–1701 | 28 | 250 | 13–22 | 160–550 | 65–75 | Forest |
| Vance River (V) | Morne L’Enfer | 1200–1702 | 28 | 250 | 13–23 | 160–550 | 65–75 | River |
| Site | Description | |||||||
| P1 | Natural seep/mud volcano | |||||||
| F1 | Manmade seep—abandoned oil well | |||||||
| F2 | Natural oil seep | |||||||
| V1 | Heavily oiled soil—pipeline contamination | |||||||
| V2 | Heavily oiled soil—pipeline contamination | |||||||
| V3 | Heavily oiled soil—natural seep | |||||||
| V4 | Heavily oiled soil—effluent contamination | |||||||
| V5 | Heavily oiled soil—effluent contamination | |||||||
| Locality | Site | No. of Soil Microbes Recovered | Crude-Oil-Utilizing Microbes | Selected Microbes | ||||
|---|---|---|---|---|---|---|---|---|
| Fungi | Bacteria Co-cultures | Fungi | Bacteria Co-cultures | Yeast * | Fungi * | |||
| Pablito (P) | P | 29 | 6 | 1 | 4 | 1 | - | 1 |
| Fyzabad (F) | F1 | 128 | 50 | 12 | 35 | 12 | 9 | 1 |
| F2 | 33 | 11 | 10 | 6 | 10 | 9 | 1 | |
| Vance (V) | V1 | 16 | 5 | 1 | 5 | 1 | 1 | - |
| V2 | 17 | 9 | 2 | 3 | 2 | - | - | |
| V3 | 52 | 19 | 2 | 14 | 2 | - | 2 | |
| V4 | 33 | 8 | 3 | 4 | 3 | 3 | - | |
| V5 | 50 | 20 | 2 | 19 | 2 | 1 | 1 | |
| Total | 358 | 128 | 33 | 90 | 33 | 23/33 | 6/33 | |
| Total | 161 isolates | 123 isolates 152 microbes | 23 | 6 | ||||
| N | Mean | SE Mean | Std. Dev | Minimum | Maximum | Grouping * | |
|---|---|---|---|---|---|---|---|
| Media type | |||||||
| PDA | 114 | 5.395 | 0.245 | 2.621 | 1.340 | 13.803 | A |
| BHA | 122 | 4.702 | 0.268 | 2.955 | 0.409 | 14.91 | A |
| Fungi | |||||||
| P | 31 | 0.161 | 0.082 | 0.454 | 0 | 2 | B |
| F1 | 31 | 1.161 | 0.473 | 2.634 | 0 | 14 | A |
| F2 | 31 | 0.226 | 0.111 | 0.617 | 0 | 3 | B |
| V1 | 31 | 0.161 | 0.105 | 0.583 | 0 | 3 | B |
| V2 | 31 | 0.097 | 0.071 | 0.396 | 0 | 2 | B |
| V3 | 31 | 0.516 | 0.300 | 1.671 | 0 | 8 | B |
| V4 | 31 | 0.129 | 0.077 | 0.428 | 0 | 2 | B |
| V5 | 31 | 0.645 | 0.205 | 1.142 | 0 | 5 | A |
| Yeast | |||||||
| P | 5 | 0.000 | 0.000 | 0.000 | 0 | 0 | B |
| F1 | 5 | 1.800 | 0.917 | 2.049 | 0 | 4 | A |
| F2 | 5 | 1.800 | 0.583 | 1.304 | 0 | 3 | A |
| V1 | 5 | 0.200 | 0.200 | 0.447 | 0 | 1 | B |
| V2 | 5 | 0.000 | 0.000 | 0.000 | 0 | 0 | B |
| V3 | 5 | 0.000 | 0.000 | 0.000 | 0 | 0 | B |
| V4 | 5 | 0.600 | 0.400 | 0.894 | 0 | 2 | A B |
| V5 | 5 | 0.200 | 0.200 | 0.447 | 0 | 1 | A |
| Microbe | Isolate | Rhodamine Intensity * |
|---|---|---|
| Fungi | F1 40 | +++ |
| V2 5 | + | |
| Bacteria | F1 1 | ++ |
| F1 6 | - | |
| V2 1 | ++ | |
| Yeast | F1 7 | - |
| F1 9 | + |
| Site | P | F1 | F2 | V1 | V2 | V3 | V4 | V5 | Sum |
|---|---|---|---|---|---|---|---|---|---|
| Aspergillus | 0 | 14 | 0 | 0 | 0 | 1▪ | 1 | 2▪ | 18 |
| Chaetomella | 0 | 1 | 0 | 0 | 0 | 0 | 0 | 0 | 1 |
| Cladosporium | 1 | 0 | 1 | 1 | 0 | 0 | 0 | 0 | 3 |
| Cochliobolus | 0 | 1 | 0 | 0 | 0 | 0 | 0 | 1 | 2 |
| Diaporthe | 0 | 0 | 0 | 0 | 0 | 1 | 0 | 0 | 1 |
| Epicoccum | 0 | 0 | 3 | 0 | 0 | 0 | 0 | 1 | 4 |
| *** Eutypella | 1 | 0 | 0 | 0 | 0 | 0 | 0 | 0 | 1 |
| Fusarium | 0 | 3 | 0 | 1 | 0 | 0 | 0 | 0 | 4 |
| Gongronella | 0 | 0 | 0 | 0 | 0 | 0 | 0 | 1 | 1 |
| Microsphaeropsis | 0 | 1 | 0 | 0 | 0 | 0 | 0 | 0 | 1 |
| Myrothecium | 0 | 0 | 0 | 0 | 0 | 0 | 0 | 3 | 3 |
| Neoascochyta | 0 | 1 | 0 | 0 | 0 | 0 | 0 | 0 | 1 |
| Neocosmospora | 0 | 0 | 0 | 0 | 0 | 0 | 0 | 1 | 1 |
| Oudemansiella | 0 | 0 | 1 | 0 | 0 | 0 | 0 | 0 | 1 |
| Paraconiothyrium | 0 | 0 | 1 | 0 | 0 | 0 | 0 | 0 | 1 |
| Paraphaeosphaeria | 0 | 0 | 0 | 0 | 0 | 0 | 2 | 0 | 2 |
| Penicillium | 0 | 2 | 0 | 0 | 0 | 8 | 0 | 5 | 15 |
| Perenniporia | 0 | 0 | 0 | 3 | 0 | 0 | 0 | 0 | 3 |
| Periconia | 0 | 0 | 0 | 0 | 1 | 0 | 0 | 0 | 1 |
| Phanerochaete | 0 | 2▪ | 0 | 0 | 0 | 0 | 0 | 0 | 2 |
| Phoma | 0 | 0 | 0 | 0 | 0 | 0 | 0 | 2 | 2 |
| Phytophthora | 0 | 0 | 1▪ | 0 | 0 | 0 | 0 | 0 | 1 |
| Pyrenochaetopsis | 0 | 3 | 0 | 0 | 0 | 0 | 0 | 1 | 4 |
| Rhizopus | 0 | 0 | 0 | 0 | 0 | 1▪ | 0 | 0 | 1 |
| *** Roussoella | 2 | 0 | 0 | 0 | 0 | 0 | 0 | 0 | 2 |
| Saccharicola | 0 | 2 | 0 | 0 | 0 | 0 | 0 | 0 | 2 |
| Scedosporium | 0 | 0 | 0 | 0 | 2 | 0 | 0 | 0 | 2 |
| *** Sydowia | 1▪ | 0 | 0 | 0 | 0 | 0 | 0 | 0 | 1 |
| Talaromyces | 0 | 2 | 0 | 0 | 0 | 5 | 0 | 1 | 8 |
| Trichoderma | 0 | 4 | 0 | 0 | 0 | 0 | 0 | 2 | 6 |
| Westerdykella | 0 | 0 | 0 | 0 | 0 | 0 | 1 | 0 | 1 |
| Fungi Sum | 5 | 36 | 7 | 5 | 3 | 16 | 4 | 20 | 96 |
| Cryptococcus | 0 | 1 | 3 | 1 | 0 | 0 | 0 | 0 | 5 |
| * Lecythophora | 0 | 4 | 3 | 0 | 0 | 0 | 0 | 1 | 8 |
| Moesziomyces | 0 | 0 | 0 | 0 | 0 | 0 | 2 | 0 | 2 |
| •Rhodotorula | 0 | 4 | 2 | 0 | 0 | 0 | 1 | 0 | 7 |
| Sakaguchia | 0 | 0 | 1 | 0 | 0 | 0 | 0 | 0 | 1 |
| Yeast Sum | 0 | 9 | 9 | 1 | 0 | 0 | 3 | 1 | 23 |
| Burkholderia | 0 | 4 | 0 | 0 | 0 | 0 | 0 | 0 | 4 |
| Chryseobacterium | 0 | 1 | 0 | 0 | 0 | 0 | 0 | 0 | 1 |
| Janthinobacterium | 1 | 7 | 9 | 1 | 0 | 0 | 3 | 1 | 22 |
| Serratia | 0 | 0 | 1 | 0 | 2 | 2 | 0 | 1 | 6 |
| Bacteria Sum | 1 | 12 | 10 | 1 | 2 | 2 | 3 | 2 | 33 |
| Total Microbial Sum | 152 |
| Taxonomy | Rank | A | % | Taxonomy | Rank | A | % |
|---|---|---|---|---|---|---|---|
| PHYLA | GENUS | ||||||
| Filamentous Fungi | Filamentous Fungi | 96 | 80.672 | ||||
| Ascomycota | 1 | 87 | 90.625 | Aspergillus | 1 | 18 | 18.750 |
| Basidiomycota | 2 | 6 | 6.250 | Penicillium | 2 | 15 | 15.625 |
| Mucoromycota | 3 | 2 | 2.083 | Talaromyces | 3 | 8 | 8.333 |
| Oomycota | 4 | 1 | 1.042 | Trichoderma | 4 | 6 | 6.250 |
| Total | 96 | Epicoccum | 5 | 4 | 4.167 | ||
| ANOVA | 0.195 | Fusarium | 6 | 4 | 4.167 | ||
| Yeast | Pyrenochaetopsis | 7 | 4 | 4.167 | |||
| Basidiomycota | 1 | 15 | 65.217 | Cladosporium | 8 | 3 | 3.125 |
| Ascomycota | 2 | 8 | 34.783 | Myrothecium | 9 | 3 | 3.125 |
| Total | 23 | Perenniporia | 10 | 3 | 3.125 | ||
| CLASS | Cochliobolus | 11 | 2 | 2.083 | |||
| Filamentous Fungi | Paraphaeosphaeria | 12 | 2 | 2.083 | |||
| Eurotiomycetes | 1 | 45 | 46.875 | Phanerochaete | 13 | 2 | 2.083 |
| Dothideomycetes | 2 | 27 | 28.125 | Phoma | 14 | 2 | 2.083 |
| Sordariomycetes | 3 | 14 | 14.583 | Roussoella | 15 | 2 | 2.083 |
| Agaricomycetes | 4 | 6 | 6.250 | Saccharicola | 16 | 2 | 2.083 |
| Mucoromycetes | 5 | 2 | 2.083 | Scedosporium | 17 | 2 | 2.083 |
| Oomycetes | 6 | 1 | 1.042 | Chaetomella | 18 | 1 | 1.042 |
| Leotiomycetes | 7 | 1 | 1.042 | Diaporthe | 19 | 1 | 1.042 |
| Total | 96 | Eutypella | 20 | 1 | 1.042 | ||
| ANOVA | 0.005 ** | Gongronella | 21 | 1 | 1.042 | ||
| Yeast | Microsphaeropsis | 22 | 1 | 1.042 | |||
| Sordariomycetes | 1 | 8 | 34.783 | Neoascochyta | 23 | 1 | 1.042 |
| Microbotryomycetes | 2 | 7 | 30.435 | Neocosmospora | 24 | 1 | 1.042 |
| Tremellomycetes | 3 | 4 | 17.391 | Oudemansiella | 25 | 1 | 1.042 |
| Ustilaginomycetes | 4 | 2 | 8.696 | Paraconiothyrium | 26 | 1 | 1.042 |
| Agaricomycetes | 5 | 1 | 4.348 | Periconia | 27 | 1 | 1.042 |
| Cystobasidiomycetes | 6 | 1 | 4.348 | Phytophthora | 28 | 1 | 1.042 |
| Total | 23 | Rhizopus | 29 | 1 | 1.042 | ||
| ANOVA | 0.002 *** | Sydowia | 30 | 1 | 1.042 | ||
| Westerdykella | 31 | 1 | 1.042 | ||||
| Total | 96 | 100 | |||||
| ANOVA | 1.5 × 10−5 *** | ||||||
| Yeast | 23 | 19.328 | |||||
| Lecythophora | 1 | 8 | 34.783 | ||||
| Rhodotorula | 2 | 7 | 30.435 | ||||
| Cryptococcus | 3 | 5 | 21.739 | ||||
| Moesziomyces | 4 | 2 | 8.696 | ||||
| Sakaguchia | 5 | 1 | 4.348 | ||||
| Total | 23 | 100 | |||||
| ANOVA | 0.002 ** |
Publisher’s Note: MDPI stays neutral with regard to jurisdictional claims in published maps and institutional affiliations. |
© 2021 by the authors. Licensee MDPI, Basel, Switzerland. This article is an open access article distributed under the terms and conditions of the Creative Commons Attribution (CC BY) license (https://creativecommons.org/licenses/by/4.0/).
Share and Cite
Ramdass, A.C.; Rampersad, S.N. Diversity and Oil Degradation Potential of Culturable Microbes Isolated from Chronically Contaminated Soils in Trinidad. Microorganisms 2021, 9, 1167. https://doi.org/10.3390/microorganisms9061167
Ramdass AC, Rampersad SN. Diversity and Oil Degradation Potential of Culturable Microbes Isolated from Chronically Contaminated Soils in Trinidad. Microorganisms. 2021; 9(6):1167. https://doi.org/10.3390/microorganisms9061167
Chicago/Turabian StyleRamdass, Amanda C., and Sephra N. Rampersad. 2021. "Diversity and Oil Degradation Potential of Culturable Microbes Isolated from Chronically Contaminated Soils in Trinidad" Microorganisms 9, no. 6: 1167. https://doi.org/10.3390/microorganisms9061167
APA StyleRamdass, A. C., & Rampersad, S. N. (2021). Diversity and Oil Degradation Potential of Culturable Microbes Isolated from Chronically Contaminated Soils in Trinidad. Microorganisms, 9(6), 1167. https://doi.org/10.3390/microorganisms9061167

